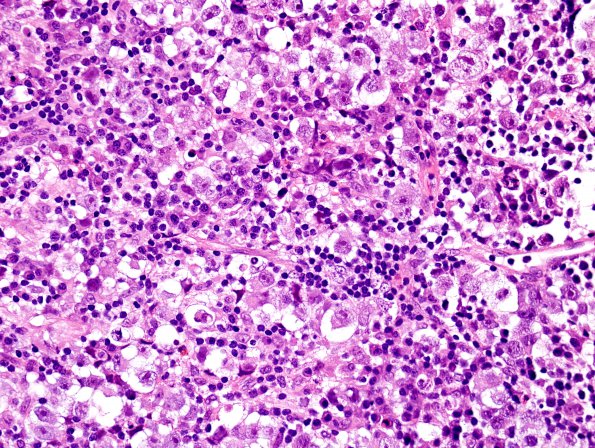
3B2 Germinoma (Case 3) H&E 2

Table of Contents
Washington University Experience | NEOPLASMS (NON-GLIAL NON-NEURONAL) | Germ Cell Neoplasm - Germinoma | 3B2 Germinoma (Case 3) H&E 2
3B2,3 The tumor consists of a dense infiltrate of benign-appearing lymphocytes and a lesser population of much larger polygonal cells with a moderate amount of pale, vacuolated cytoplasm, mildly irregular nuclear contours, finely speckled relatively open chromatin, and prominent irregular eosinophilic nucleoli. These larger cells are seen singly and in clusters throughout the specimen, and often exhibit mitotic figures. No multinucleated cells (syncytiotrophoblasts) are identified.